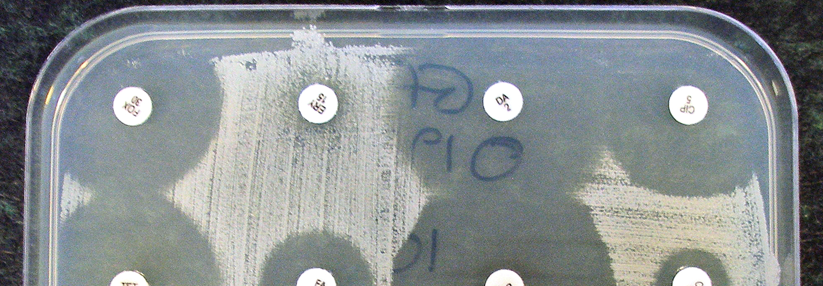

Laborbefunde nicht wie Kontoauszüge lesen!
 Wegen Messungenauigkeiten wird mancher Normalbefund pathologisch.
© iStock/luoman
Wegen Messungenauigkeiten wird mancher Normalbefund pathologisch.
© iStock/luoman
Die Richtlinie der Bundesärztekammer (RiLi-BÄK) zur Qualitätssicherung laboratoriumsmedizinischer Untersuchungen wird gerade überarbeitet. Die Änderungen sollen im nächsten Jahr in Kraft treten und die Diagnostik genauer machen.
Bislang lagen die Akzeptanzgrenzen bei der HbA1c-Bestimmung im Ringversuch für Labore nach der RiLi-BÄK bei 18 %. Das entspricht nicht dem Anspruch für eine klinische Entscheidung. Viele Normalbefunde werden so als pathologisch eingestuft, monierte Dr. Patricia Kaiser, Leiterin des Referenzlabors der Gesellschaft zur Förderung der Qualitätssicherung in medizinischen Laboratorien e.V.
In den von ihr koordinierten regelmäßigen Ringversuchen stieg inzwischen der Anteil der Labore, die unter einem Level von 8 % bleiben. Weniger starke Messungenauigkeiten sind aber nur die eine Seite der Medaille, erklärte Dr. Kaiser. Bei jedem Ringversuch passieren auch andere Fehler, z.B. gehen Proben verloren, werden vertauscht oder anderweitig unkorrekt behandelt.
Beim Ringversuch im Januar 2018 betraf das 12 % der Messungen mit 8 %-Akzeptanzgrenze. „Die meisten Geräte auf dem Markt sind gut, Abweichungen oder fehlerhafte Bestimmungen sind selten. Die Hauptprobleme liegen in den einzelnen Laboren“, stellte Dr. Kaiser klar. Sie forderte aber auch, dass die wenigen Systeme, die den in der künftigen RiLi-Bäk vorgesehenen 8 %-Level nicht schaffen, entsprechend weiterentwickelt werden müssen.
„Wir haben kein System, das zuverlässig ist“
Auch bei der Bestimmung von LDL und HDL gibt es eine relevante Messungenauigkeit, die von vielen Ärzten unterschätzt wird. „Wir haben kein System, das zuverlässig ist“, betonte Professor Dr. Matthias Nauck, Institut für Klinische Chemie und Laboratoriumsmedizin der Universitätsmedizin Greifswald. Er warnte davor, die Laborwerte wie einen Kontoauszug zu lesen und schlug vor, die minimale Differenz als statistische Größe mit anzugeben.
Dadurch kann man eher abschätzen, ob es sich bei einem erhöhten oder erniedrigten Wert tatsächlich um eine Veränderung beim Patienten handelt – oder nur um eine Schwankung innerhalb der Messunsicherheit. Die RiLi-BÄK 2019 soll erstmals LDL und HDL mit aufführen. Prof. Nauck schlug als akzeptable Schwankungen 6 % bzw. 8 % vor. Im Ringversuch 2010 war selbst eine Akzeptanzgrenze von 12 % teilweise deutlich überschritten worden.
Angabe der Messungenauigkeit von den Laboren fordern
Grenzwerte für Diagnose und Monitoring sind notwendig, das wird durch solche Befunde der Messunsicherheit nicht infrage gestellt, betonten die Labormediziner. Aber sie empfehlen, in der Praxis mehr in „Graubereichen“ zu denken. Um diese besser einschätzen zu können, sollten Ärzte von den Laboren die Angabe der Messungenauigkeit fordern. Außerdem sollten sie klinische Entscheidungen möglichst nicht aufgrund eines einzigen Wertes treffen, sondern wiederholte Messungen zugrunde legen.
Quelle: Diabetes Kongress 2018